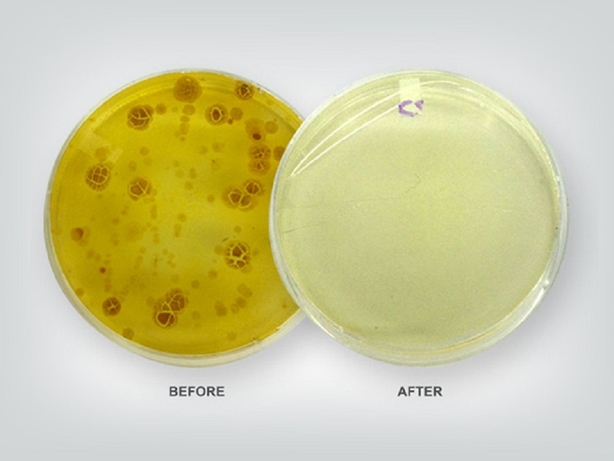

PhoneSoap Charger
Manufacturer : N/A
Released : 2014
Price : $59.95
สมาร์ทโฟนถือว่าเป็นอุปกรณ์ที่ทุกคนมีติดตัวติดกายด้วยตลอดเวลา แล้วคุณแน่ใจแล้วหรือว่าได้ทำความสะอาดสมาร์ทโฟนที่ใช้อยู่ทุกวันให้สะอาดไร้เชื้อโรค ลองหยิบสมาร์ทโฟนขึ้นมาดูซิแล้วลองสังเกตุดีดีก็จะพบคราบแห้งความสกปรกติดอยู่ สมาร์ทโฟนคู่ใจนี่แหละที่เป็นแหล่งสะสมเชื้อโรคอย่างดี
ถึงเวลาที่เราจะมาทำความสะอาดสมาร์ทโฟนให้สะอาดปราศจากเชื้อโรคกันแล้วด้วยอุปกรณ์ที่มีชื่อว่า PhoneSoap Charger ที่สามารถชาร์ตแบตเตอร์รีและทำความสะอาดสมาร์ทโฟนไปพร้อมกัน โดยระหว่างที่ชาร์ตแบตเตอร์รี่มันก็จะทำการทำความสะอาดสมาร์ทโฟนและกำจัดเชื้อโรค โดยที่ไม่ทำอันตรายต่อสมาร์ทโฟน
ซึ่ง PhoneSoap Charger จะใช้ระบบแสง UV-C ทำความสะอาดเท่านั้น ไม่ใช้ความร้อน น้ำ หรือสารเคมีใด ๆ ทั้งสิ้น จึงรับรองได้ว่าสมาร์ทโฟนจะอยู่ในสภาพดีใช้งานได้ดีตามปกติ โดยแสง UV-C นี้สามารถฆ่าทำลายเชื้อโรคขนาดเล็กได้และยังปรอดภัยต่อสมาร์ทโฟนอีกด้วย
โดยที่แสง UV-C จะมีประสิทธิภาพในการทำลายกรดนิวคลีอิกและทำลาย DNA ของเชื้อโรคทำให้เชื้อโรคตายลงไป และเพราะแสง UV-C นี้มีอันตรายต่อดวงตาของเรามันจึงต้องทำงานอยู่แต่ภายในกล่อง
PhoneSoap Charger จึงถูกออกแบบมาให้มีลักษณะเป็นกล่อง ภายในมีพื้นที่ความยาวประมาณ 6 นิ้ว กว้างประมาณ 3.74 นิ้ว และสายชาร์ตก็มีหลากหลายหัวให้เปลี่ยน ส่วนใครที่ชอบชาร์ตสมาร์ทโฟนข้ามคืนและชอบตั้งเป็นนาฬิการปลุกก็ไม่ต้องเป็นกังวลเพราะว่าด้านล่างของกล่องมีช่องให้เสียงเตือนต่าง ๆ ดังออกมาได้เหมือนเดิม
สำหรับใครที่สนใจก็สามารถเข้าไปดูรายละเอียดเพิ่มเติมหรือสั่งซื้อสินค้าได้แล้วที่ www.phonesoap.com ส่วนตัวแอดมินเองตอนนี้กระเป๋าเบาขอใช้แอลกอลฮอล์ขัด เช็ด ถูแทนไปก่อน คิดว่าคงทดแทนกันได้อยู่นะ
By Admin Soneko
-
ย้อนอดีตเกมดัง Resident Evil Outbreak : เกมซอมบี้ไอเดียดีที่มาก่อนเวลา#ResidentEvil #ResidentEvilOutbreak #Capcom #SurvivalHorror #RaccoonCity #Biohazard #PS2 #OnlineGaming #RetroGaming #ข่าวเกม
-
Resident Evil 9 : Requiem [Review / สั่งซื้อแผ่นเกม / ราคา / วันวางขาย]27 กุมภาพันธ์ 2026
-
BEYBLADE X : CX-17 Random Booster Vol.10 [สั่งซื้อ / ราคาดี / เบย์เบลดใหม่]#beybladex #kctoysbeybladex #beybladexthailand #ベイブレードX